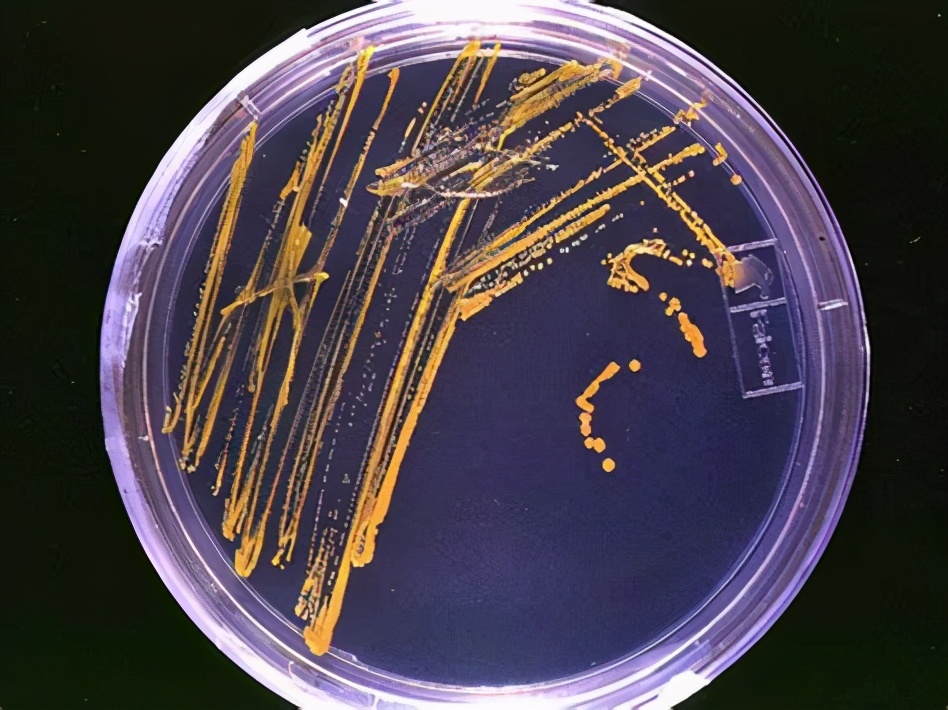
刷碗刷子长霉菌了怎么处理,刷碗布上的细菌

您好,看完这篇文章你可能需要三分钟,但是您会知道:
一、漂*粉白**。
二、加热。
三、微波炉。
在生活中,细菌可谓是无处不在,很多时候都会为我们的安全产生威胁。
有的人觉得每年出现1~2次胃肠道疾病是再正常不过的事情了,但实际上,如果注意厨房卫生这些问题,有可能避免。
特别是食物所导致的疾病,无论是感染或者食物中毒都是很严重的问题,比如微生物在繁殖中所产生的毒素,肠毒素或者神经毒素,都会被人体所吸收带来不同程度的危害。
所以医生都会建议大家注意饮食卫生安全,细菌的危害也是可以预防的,特别是在家里。
在诸多卫生问题当中,刷碗布和菜板的卫生问题是最难处理的,而且很容易滋生细菌。
特别是在狭小和潮湿的地方,细菌的繁殖获得了有利条件,如果清理不当容易让人发生感染。
很多人都想好好把这些地方的细菌处理一下,但是用什么方法更好一点呢?直接用洗洁剂擦洗?还是用热水烫一下呢?为了清除这些用品上的微生物,有什么方法可以选择呢?
今天@康复Therapy推荐3种好方法,但是各有利弊,选择自己适用的最好。
一、漂*粉白**。
看到这里你会不会想到“懂王”?他曾经说用漂*粉白**也可以治疗新型冠状病毒肺炎,虽然这种方式有点极端,但是客观上讲漂*粉白**对微生物的作用也是很强大的。
用化学物质杀死微生物可谓是一个很好的方法,比如含有氯元素的漂*粉白**,只要在1升水中加5毫升,就可以杀死大多数细菌。
很多时候,也可以用这种方式来处理厨房中的清洁用品。
但这可不是万能战术,因为含有氯的物质是有毒的,特别是粘在衣服上或者冲入下水管道中,都会对人和野生动物造成不良破坏。
所以漂*粉白**可以用,但一定要注意使用的安全性。

二、加热。
只要把温度升到60℃,热肥皂水就可以杀死很多很多细菌。
这种方法其实很简单,但是也很费力,因为必须要用热水,这个比自来水的温度要高得多,需要特意烧水。
而且浸泡的时间也有要求,一般推荐20~30分钟,但也有文献指出过,这种方法对很多有芽孢的细菌并没有用。
所以只能说加热可以处理大部分细菌,对部分细菌还是没有用的,这个方法一定要注意,并不是完全可行。
而且在用热水的时候,要注意个人防护,不要烫伤。

三、微波炉。
也有专家建议把湿海绵放在微波炉中加热,直到冒白色的蒸汽为止。
不过每个海绵吸水量和厚度不一样,所以加热的时间也有差别,但标准就是可以看到冒蒸汽。
这种方式也很有效,但一定要注意要把海绵弄湿,而且要时刻观察,否则很容易着火。
特别是对很干燥的海绵以及含有金属的海绵加热发生火灾的情况是很严重的。
而且也要注意不要把手烫伤,可以用夹子或者筷子来把海绵拿出来。

这些方法都是很有效的,有很多微生物学家都建议类似的方法来处理刷碗布或者海绵上的细菌。
但也要注意最好用的方法其实是第3种,而使用漂*粉白**的话可能会漏到10%的细菌。
当然也可以利用自动洗碗机,既用热水消毒,也在水中加入少量漂*粉白**,效果可能也非常好。
@头条健康 #谣零零计划# #哆咖医生超能团# #健康2021#

咳嗽两周都不好,医生怀疑是肺结核,医院免费做检查,免费领药物
中医按摩,能不能治好颈椎病?医生:能,但要找对人,否则能瘫痪
乳腺癌多久筛查一次?医生:“高危人群”可以6个月就去一次医院
「手指挫伤」怎么办?医生:很多都不严重,可这类情况应该去医院